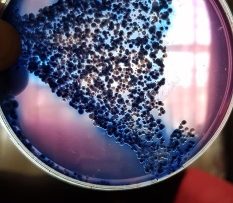

Valies drinkwater skoon, rivier nie
Vaalweekblad 15 Mei bls 7

VANDERBIJLPARK. – AfriForum se Blou- en Groendruppel-projek vir 2019 is op 7 Mei gedoen. Dit het ten doel om die watergehalte in die gebied te monitor. Die Bloudruppel-projek toets die kwaliteit van die dorp se drinkwater en die Groendruppel-projek die kwaliteit van rioolwater in die dorp.
Lede van AfriForum Vanderbijlpark en Vereeniging, Ruan Oosthuizen (omgewingskoördineerder Vanderbijlpark), Hennie van Eck (omgewingskoördineerder Vereeniging) en De Wet Ungerer (AfriForum hoofkantoor) het die projek by verskeie plekke in en om Vanderbijlpark en Vereeniging gedoen. Bloudruppel: Hoërskool Overvaal * Trimed * Elite Auto * Die rivier by Stonehaven-op-Vaal * AGS Dinamika
* Pioneer House Groendruppel: * Die rivier by Stonehaven-on-Vaal * Leeukuil afvalwateraanleg * Rietspruit afvalwateraanleg * Sebokeng afvalwateraanleg Hoërskool Overvaal, Trimed, Elite Auto, AGS Dinamika en die Pioneer House is getoets vir nitraat konsentrasies (enige sout of ester (samestelling) van salpetersuur) en voldoen aan nasionale standaarde.
Leeukuil-, Rietspruit-, Sebokeng- en die rivier by Stonehaven-on-Vaal is getoets vir nitraat konsentrasies en voldoen nie aan nasionale standaarde nie. Alle gebiede wat getoets is vir fosfaatkonsentrasies (enige sout of ester van fosforsuur) voldoen aan nasionale standaarde, behalwe die Leeukuil- en Sebokeng-afvalwateraanleg. Enteriese bakterieë is by vier gebiede waar toetse uitgevoer is, aangetref. Hulle is weer eens die Rietspruit-, Sebokeng-, Leeukuil- en die Vaalrivier by Stonehaven- on-Vaal. Faecal Coliform (menslike en dierlike organismes van rou riool) is in vyf blouproewe gevind in gebiede waar toetse uitgevoer is. Dit is weer eens Rietspruit-, Sebokeng-, Leeukuil- en die Vaalrivier by Stonehavenon- Vaal. E.Coli is ‘n bakterie wat in die laer dermkanaal van warmbloedige organismes voorkom en siektetoestande tot gevolg kan hê. Die Suid-Afrikaanse Nasionale Standaarde laat geen E.Coli toe vir drinkwater nie. Uit bogenoemde inligting is dit dus duidelik waar die probleemgebiede is wat die besoedeling van riool betref, en dat daar daadwerklike ingryping nodig is om die R241 miljoen wat vir die gebied bewillig is om die rioolkrisis op te los, nou aangewend sal moet word om die Vaaldriehoek van totale ondergang te red. Een positiewe aspek is darem dat ons water vir huishoudelike gebruik nog skoon is.
VANDERBIJLPARK. – “Al hoe die probleem opgelos kan word, is as die Emfuleni Plaaslike Munisipaliteit die opgradering van die riool infrastruktuur in werking stel. AfriForum sal deurlopend die ondersoekbeampte gemoeid met Omgewingsake help en bystaan om druk op die munisipaliteit te plaas om te verseker dat die nodige herstelwerk van stapel gestuur word.” Dit is die reaksie van AfriForum na die onlangse vrystelling van die 2019 Blou- en Groendruppel-verslag. Volgens AfriForum blyk dit uit die toetse dat die gehalte van die drinkwater nog op goeie standaard is. Die rioolwater (wat by die uitlaatpyp van die rioolwerke wat terug in die rivier gepomp word uitkom nadat dit gesteriliseer en skoongemaak is), lyk veel slegter as wat dit in 2018 was. “Dit is duidelik wat op die oomblik in die Vaalrivier aangaan. Dit word glad nie aanbeveel dat mense enige watersport wat direkte kontak met rioolwater het, beoefen nie. Dit het ‘n negatiewe uitwerking op toerisme in die gebied en moontlik ook op die waarde van eiendom aan die oewer van die Vaalrivier. Ons is ook bewus dat generasies van visspesies weens die besoedeling gevrek het. Ons het verlede jaar reeds strafregtelike klagtes teen Emfuleni aanhangig gemaak. Die saak is tans by die ondersoekbeampte gemoeid met Omgewingsake en ons dat hulle dit in ‘n ernstige lig sien.”
bakterie
Faecal
Coliform.

on-Vaal gedoen. Foto’s: AfriForum.

en dier in.



